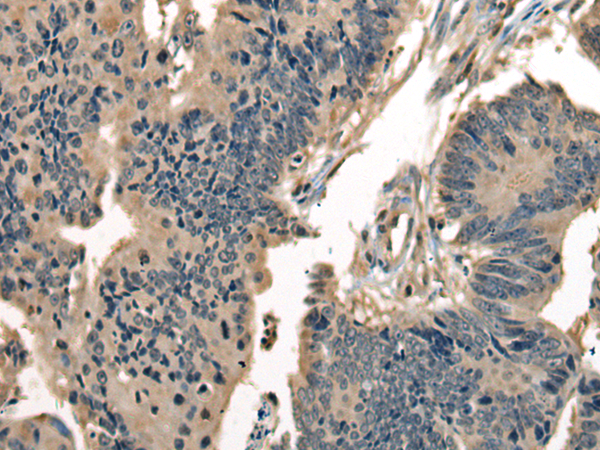

中文名稱:兔抗DNAJC2多克隆抗體
Background:
This gene is a member of the M-phase phosphoprotein (MPP) family. The gene encodes a phosphoprotein with a J domain and a Myb DNA-binding domain which localizes to both the nucleus and the cytosol. The protein is capable of forming a heterodimeric complex that associates with ribosomes, acting as a molecular chaperone for nascent polypeptide chains as they exit the ribosome. This protein was identified as a leukemia-associated antigen and expression of the gene is upregulated in leukemic blasts. Also, chromosomal aberrations involving this gene are associated with primary head and neck squamous cell tumors. This gene has a pseudogene on chromosome 6. Alternatively spliced variants which encode different protein isoforms have been described.
Applications:
ELISA, IHC
Name of antibody:
DNAJC2
Immunogen:
Synthetic peptide of human DNAJC2
Full name:
DnaJ heat shock protein family (Hsp40) member C2
Synonyms:
ZRF1; ZUO1; MPP11; MPHOSPH11
SwissProt:
Q99543
ELISA Recommended dilution:
5000-10000
IHC positive control:
Human colorectal cancer and human ovarian cancer
IHC Recommend dilution:
30-150

購物車
幫助
021-54845833/15800441009
